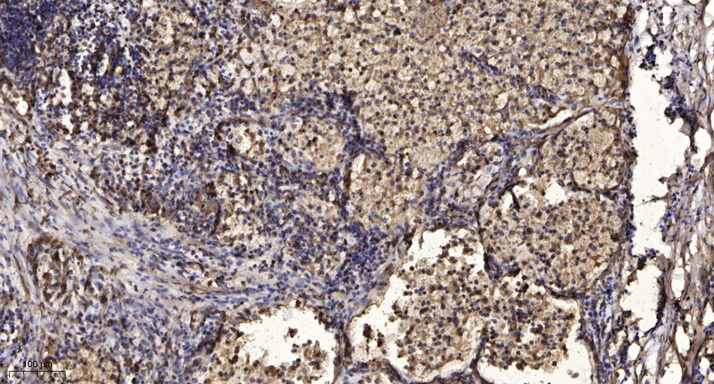

- 生化试剂
- ELISA检测
-
抗体蛋白
二抗生物素标记 过氧化物酶(HRP)标记 胶体金试剂 FITC荧光标记 RBITC荧光标记 二抗免疫血清 其它荧光标记二抗 藻红蛋白(PE)荧光标记 胶体金(Gold)标记 SAlexa Fluor荧光系列 碱性磷酸酶(AP)标记 别藻蓝蛋白(APC)荧光标记 其它标记 PE标记二抗 DyLight标记二抗 AU标记二抗 Biotin标记二抗 AMCA标记二抗 Texas Red标记二抗 TRITC标记二抗 HRP标记二抗 未标记二抗 Cy标记二抗 AbBox Fluor标记二抗内参抗体 小分子抗体抗体标记试剂盒细菌抗体蛋白病毒包装试剂杂交瘤融合筛选WB、IHC、ELISA相关试剂细胞培养试剂病原微生物抗原抗体假病毒抗体校准品其他抗原抗体标记的标签抗体病理级IHC抗体重组蛋白
- 细胞培养
- 实验耗材
- 仪器设备
- 生化试剂盒
- 小分子试剂
- 基质胶
-
斑马鱼产品
订货时间:周一至周五
订货Q Q:79688691
订货邮件:79688691@qq.com
产品简介-
货号IM54301
-
别名MAP2K7; JNKK2; MEK7; MKK7; PRKMK7; SKK4; Dual specificity mitogen-activated protein kinase kinase 7; MAP kinase kinase 7; MAPKK 7; JNK-activating kinase 2; MAPK/ERK kinase 7; MEK 7; Stress-activated protein kinase kinase 4; SAPK kinase 4; S
-
产品名称MEK-7 Rabbit Polyclonal Antibody
-
类别抗体产品
-
基因名称MAP2K7
-
蛋白名称Dual specificity mitogen-activated protein kinase kinase 7
-
ClonalityPolyclonal
-
推荐应用WB,IHC-P
-
反应种属Human,Mouse,Rat
-
浓度1 mg/ml
-
存储缓冲液Liquid in PBS containing 50% glycerol, 0.5% BSA and 0.02% New type preservative N.
-
Human Gene ID5609
-
Human Swissprot No.O14733
-
Mouse Gene ID26400
-
Mouse Swissprot No.Q8CE90
-
Rat Gene ID363855
-
Rat Swissprot No.Q4KSH7
-
免疫原The antiserum was produced against synthesized peptide derived from human MAP2K7. AA range:241-290
-
特异性MEK-7 Polyclonal Antibody detects endogenous levels of MEK-7 protein.
-
稀释度WB 1:500-2000, IHC-P 1:50-300
-
预测分子量47kDa
-
宿主Rabbit
-
同种型Rabbit,IgG
-
背景介绍The protein encoded by this gene is a dual specificity protein kinase that belongs to the MAP kinase kinase family. This kinase specifically activates MAPK8/JNK1 and MAPK9/JNK2, and this kinase itself is phosphorylated and activated by MAP kinase kinase kinases including MAP3K1/MEKK1, MAP3K2/MEKK2,MAP3K3/MEKK5, and MAP4K2/GCK. This kinase is involved in the signal transduction mediating the cell responses to proinflammatory cytokines, and environmental stresses. Alternative splicing results in multiple transcript variants. [provided by RefSeq, Jul 2014],
-
组织表达Ubiquitous; with highest level of expression in skeletal muscle. Isoform 3 is found at low levels in placenta, fetal liver, and skeletal muscle.
-
细胞定位Nucleus. Cytoplasm .
-
信号通路MAPK_ERK_Growth;MAPK_G_Protein;ErbB_HER;Toll_Like;T_Cell_Receptor;Fc epsilon RI;Neurotrophin;GnRH;
-
功能catalytic activity:ATP + a protein = ADP + a phosphoprotein.,cofactor:Magnesium.,enzyme regulation:Activated by phosphorylation by specific MAP kinase kinase kinases such as MAP3K1/MEKK1, MAP3K3/MEKK3, MAP3K11/MLK3 and MAP3K12/DLK.,function:Stress activated, dual specificity kinase that activates the JUN kinases MAPK8/JNK1, MAPK9/JNK2 and MAPK10/JNK3.,PTM:Activated by phosphorylation on Ser/Thr.,similarity:Belongs to the protein kinase superfamily. STE Ser/Thr protein kinase family. MAP kinase kinase subfamily.,similarity:Contains 1 protein kinase domain.,tissue specificity:Ubiquitous; with highest level of expression in skeletal muscle. Isoform 3 is found at low levels in placenta, fetal liver, and skeletal muscle.,
-
纯化The antibody was affinity-purified from rabbit antiserum by affinity-chromatography using epitope-specific immunogen.
储存与保存1.保存:-20℃
2.有效期:1年
注意事项1.我司生产的生化试剂如无特殊标注,基本为非无菌包装,若用于细胞实验,请提前做好预处理。需低温保存的产品,一旦配成溶液,请分装保存,避免反复冻融造成的产品失效。
2.本产品仅供科研使用。请勿用于医药、临床诊断或治疗,食品及化妆品等用途。请勿存放于普通住宅区。
3.为了您的安全和健康,请穿好实验服并佩戴一次性手套和口罩操作。
4.实验结果可由多种因素影响,相关处理只限于产品本身,不涉及其他赔偿。
备注:由于产品信息可能会有优化升级,请以实际收货标签信息为准。
-
NF-κB p65 (Phospho Ser536) (14B13) Rabbit Monoclonal Antibody¥1300.00货号:IM72029 -
PI3-Kinase p110α (11A15) Rabbit Monoclonal Antibody¥1300.00货号:IM72028 -
FAP (6L4) Rabbit Monoclonal Antibody¥1300.00货号:IM72027 -
KANSL1L Rabbit polyclonal antibody¥1400.00货号:IM72021 -
CD46 Recombinant Rabbit mAb¥1400.00货号:IM72020